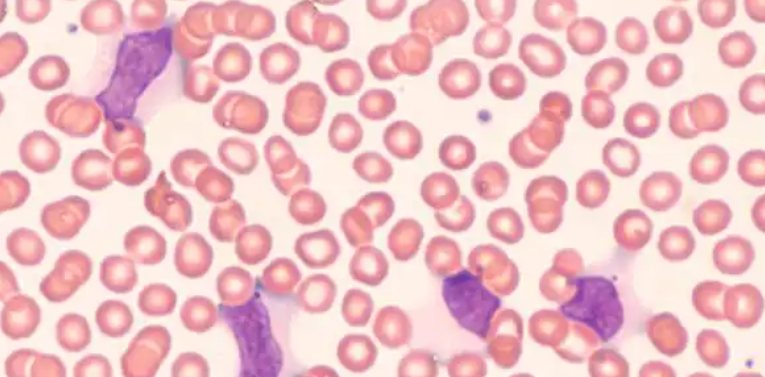

传染性单核细胞增多症是一种常见的传染性疾病,主要是由EB病毒引起的。EB病毒是一种人类疱疹病毒-4型,它能够通过唾液、血液和其他体液传播,人群普遍易感。一旦感染,患者的血液中就会出现大量单核细胞,这就是传染性单核细胞增多症的特征之一。
传染性单核细胞增多症通常发生在青少年和成年人,而儿童很少受到影响。一些常见的症状包括发热、喉咙痛、头痛、乏力和淋巴结肿大。一:这些症状可能持续数周到数个月不等,严重时甚至会影响到个人的正常生活和工作。二:尽管传染性单核细胞增多症本身并不是一种严重的疾病,但在某些人群中,如免疫系统受损的患者,症状可能更加严重,甚至发展成为其他严重的并发症。
EB病毒通过唾液传播是主要途径之一,所以在疫情期间,我们需要采取一些预防措施来减少感染的风险。三:首先,我们应该避免与患者过于亲密的接触,尤其是分享餐具、水杯等物品。其次,保持良好的个人卫生习惯,如勤洗手、使用纸巾或袖子遮住口鼻咳嗽和打喷嚏。最后,加强免疫力,均衡饮食、合理锻炼、保持良好的睡眠习惯对于提升免疫力是有帮助的。
对于已经感染了EB病毒的个体,我们需要进行一些治疗以减轻症状和促进康复。一般情况下,具体的治疗方案需要根据患者的具体情况来定制。二:医生通常建议患者休息,多饮水,服用退烧药或止痛药来缓解症状。此外,患者还需要注意营养摄入,尽可能多地摄入富含维生素和矿物质的食物来维持身体健康。如果患者有其他并发症,如扁桃体炎或肝炎,医生可能会给予相应的治疗。
尽管传染性单核细胞增多症是一种常见的疾病,但我们可以通过预防和治疗来减少其对我们的影响。一:通过避免与已感染的患者过于亲密接触,保持良好的个人卫生习惯和加强免疫力,我们可以降低感染的风险。二:一旦感染,我们应该及时就医并按医生的建议进行治疗。只有这样,我们才能更好地应对传染性单核细胞增多症,并尽快康复。
总之,传染性单核细胞增多症是一种常见的传染性疾病,容易通过EB病毒传播。它可以引起一系列的症状,但通常不会对患者的生命造成严重威胁。然而,在某些人群中,如免疫系统受损的患者,症状可能变得更加严重。通过预防和治疗措施,我们可以减少传染性单核细胞增多症对我们的影响,并加快康复进程。三:因此,我们应该加强个人卫生习惯,避免与感染者过度接触,并在感染后及时就医。只有这样,我们才能有效地应对这种疾病。
云作文原创内容,未经允许不得转载。